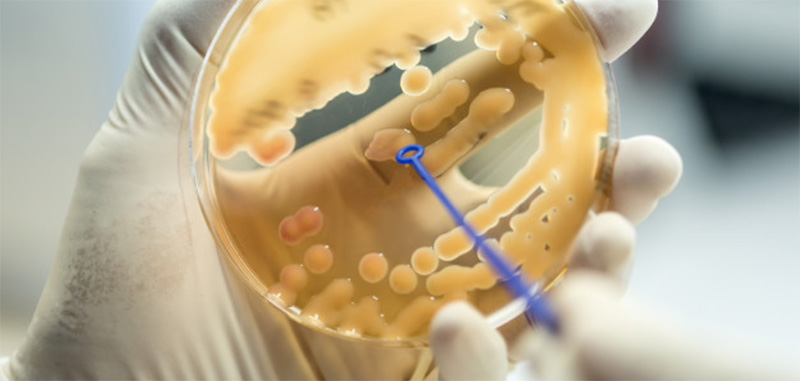

Podemos entender a resistência microbiana como fenômeno caracterizado pela capacidade dos microorganismos — bactérias, fungos, parasitas, etc. — de sobreviver ao efeito dos antimicrobianos.
O resultado é a redução ou eliminação da eficiência do medicamento ou desinfetante utilizado, seja no tratamento de enfermidades ou higienização de superfícies.
As consequências desse problema variam entre a contaminação de produtos — especialmente aqueles produzidos pela indústria alimentícia — e o agravamento de doenças, que em casos extremos pode levar a óbito.
Essa resistência se divide entre resistência intrínseca, que consiste nos mecanismos de resistência naturais do microorganismo, e adquirida, ou seja, aquela desenvolvida a partir de mutações nos próprios genes.
Nesse sentido, é por essa e outras razões que se faz tão necessário seguir as diretrizes de higienização estipuladas pela Anvisa (Agência Nacional de Vigilância Sanitária), sobretudo para os negócios que atuam no ramo de produção de alimentos e bebidas.
Veja a seguir como prevenir seu empreendimento!
Saiba como higienizar os ambientes
Na indústria alimentícia, os produtos químicos são usados regularmente para desinfetar — destruir microorganismos — e sanitizar — reduzir a presença de microrganismos a níveis seguros — superfícies de contato do produto.
Estas são as medidas necessárias para garantir que os alimentos consumidos estarão protegidos contra microrganismos que possam causar doenças ao consumidor.
Para obter o nível exigido de desinfecção ou desinfecção, o produto químico em questão deve ser aplicado a uma determinada concentração por um determinado período de tempo.
Esses parâmetros são descritos no rótulo do produto e devem ser seguidos para obter o controle desejado.
O processo de sanitização depende do tipo de superfície em questão. A maioria dos desinfetantes deve ser aplicada às superfícies livres de matéria orgânica e resíduos de limpeza.
A ordem correta de higienização indicada é enxaguar, lavar, enxaguar e desinfetar. O detergente usado na fase de limpeza deve ser adequado para o tipo de resíduo.
Conheça os melhores produtos desinfetantes
Confira a seguir quais são os produtos mais eficazes contra grande parte dos microorganismos.
Hipoclorito
Sua alta eficácia e seu baixo custo de produção tornam o hipoclorito o desinfetante mais utilizado no ramo industrial. Ele é o composto mais comum e é um ótimo desinfetante, pois é um forte oxidante.
O hipoclorito causa ampla mortalidade microbiana, destruindo sua membrana externa, causando perda de controle da permeabilidade e possível lise da célula.
Dióxido de cloro
Este composto inorgânico é um desinfetante bastante eficaz contra bactérias, fungos e vírus. É um oxidante que reage com proteínas e ácidos graxos dentro da membrana celular, resultando em perda de controle de permeabilidade e interrupção da síntese de proteínas.
Em comparação com o hipoclorito, o dióxido de cloro requer concentrações muito menores para alcançar a mortalidade microbiana.
Iodóforos
Estes compostos são menos ativos que o hipoclorito, mas são desinfetantes igualmente eficientes contra a resistência microbiana. Os iodóforos se ligam a radicais sulfúricos de proteínas, como cisteína, causando danos à parede celular.
Infelizmente, esses compostos mancham facilmente as superfícies, especialmente as de plástico.
Ácido peracético
Também conhecido como PAA, é um desinfetante eficaz contra muitos microorganismos e seus esporos. A mortalidade é gerada pela ruptura de compostos químicos na membrana celular.
Este desinfetante funciona bem em condições frias (~ 4° C), criando uma boa taxa de mortalidade microbiana em equipamentos mantidos abaixo da temperatura ambiente.
Descubra como combater a resistência aos sanitizantes
Sempre que um produto químico é usado para produzir mortalidade de microorganismos, é possível que ele promova a resistência microbiana adquirida. Isso acontece quando nem todos os microrganismos são mortos.
Nesse cenário, é preciso tomar medidas de desinfecção de superfícies mais agressivas. É necessário avaliar os microorganismos presentes para que o desinfetante adequado seja utilizado nas quantidades adequadas e pelo tempo recomendado.
Gostou deste conteúdo? Então, acesse nossa página e fique por dentro dos últimos conteúdos sobre o assunto!